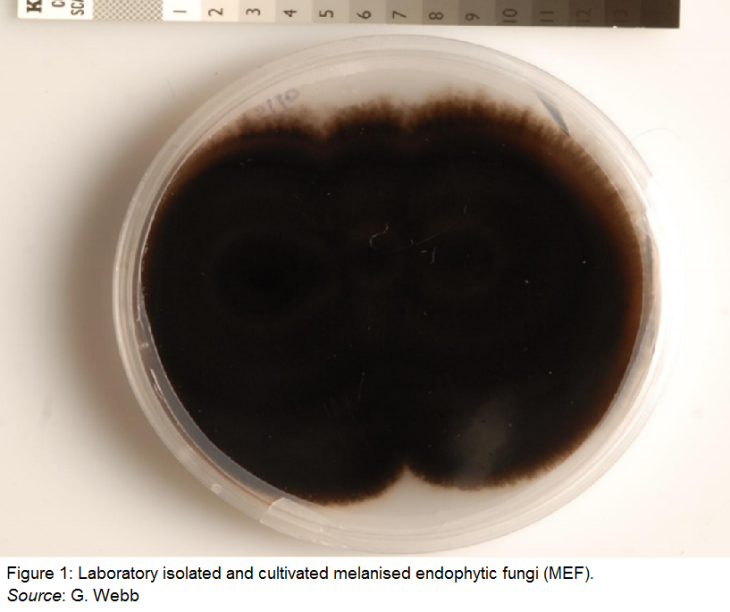
Káº¿t quáº£ hÃ¬nh áº£nh cho melanised endophytic fungi

Fungi Is The Latest And Probably Ultimate Solution To CO2 Problem
Dhir Acharya - Dec 27, 2018
These farmers are working with scientists to implement carbon sequestration into agriculture, hopefully decreasing CO2 in the atmosphere.
- Going Vegetarian Could Eliminate 16 Years Of CO2 Emissions By 2050
- CO2 Can Be Turned Into Sustainable Fuel, Giving Hope To Polluted Delhi
- These Living Bricks Can Self-Heal, Absorb CO2, And Multiply
Carbon dioxide level in the atmosphere has risen so high that scientists are relentlessly searching for effective solutions to tackle this matter. One of them is a process called carbon sequestration, where carbon is captured. Hence removed from the air and stored for a long time.
In Australian, a team of farmers is working with scientists to take advantage of fungi’s power in soils. Considering the dry conditions of Australia, raising the carbon levels in soils can help keep more water, hence boost the farming conditions.

Guy Webb, a researcher at SoilCQuest
Apparently, when more carbon is kept in the soil, there is more fresh air, solving the issue of greenhouse gases, global warming, and climate change.
In Forbes and Trangie, New South Wales, in Jack Farthing and Mick Wettenhall have trialed large plots planted with newly isolated fungi to conduct carbon sequestration in mass volume on their farm animals as well as grains properties at their farms.
Initially, a research team from the University of Sydney, led by Peter McGee, isolated the fungi in soils in Sydney Basin and trialed the process in their lab.
The research was then published in Soil Research, reporting that certain strains of MEF (melanized endophytic fungi) can potentially raise organic carbon levels in lab experiments with controlled soil. MEFs, aka dark septate endophytes, are a large group of species living in plants that produce melanin. This melanin is a stable form of carbon which doesn’t easily break down like linear carbon compounds.
When this kind of fungi is integrated into the soil, it not only raises the levels of soil carbon but also helps store carbon in the long term.
The research previously in the lab has now made its way to field tests.
First, researchers inoculate the fungi into plant seeds. Next, they put these seeds into a planter, and later they sow them.
It is claimed by the research team that when this process is implemented on larger scales, they can capture millions of tons of carbon from the atmosphere. Not-for-profit agricultural organization SoilCQuest has kept track on this new technology, hoping it will improve agricultural productivity while help tackle the carbon issue.

The research lately appeared in Grassroots, an award-winning documentary of 2018, when it was shown at SCINEMA film festival in Australia.
Guy Webb, a researcher at SoilCQuest, says soil microbiology is a scientific area that has been underrated for a long time.
He added that we know little about the complex ecosystem underground while the plants we eat rely on the interaction with tiny organisms like fungi, nematodes, and bacteria, to live.
According to Webb, the soil is the most massive sink for terrestrial carbon on Earth, and farmers, who manage it are affected the most by climate change.
Back on the farm, Wettenhall, as a farmer, says it’s vital to rapidly implement these measures in agriculture since increasing soil carbon levels is the only way out for them.
Apparently, farmers like Farthing and Wettenhall must develop reliable and feasible technologies for agriculture to have a future.
Featured Stories
Features - Mar 24, 2026
How to Use GeForce NOW to Play Video Games Without Actual Hardware
Features - Jan 29, 2026
Permanently Deleting Your Instagram Account: A Complete Step-by-Step Tutorial
Features - Jul 01, 2025
What Are The Fastest Passenger Vehicles Ever Created?
Features - Jun 25, 2025
Japan Hydrogen Breakthrough: Scientists Crack the Clean Energy Code with...
ICT News - Jun 25, 2025
AI Intimidation Tactics: CEOs Turn Flawed Technology Into Employee Fear Machine
Review - Jun 25, 2025
Windows 11 Problems: Is Microsoft's "Best" OS Actually Getting Worse?
Features - Jun 22, 2025
Telegram Founder Pavel Durov Plans to Split $14 Billion Fortune Among 106 Children
ICT News - Jun 22, 2025
Neuralink Telepathy Chip Enables Quadriplegic Rob Greiner to Control Games with...
Features - Jun 21, 2025
This Over $100 Bottle Has Nothing But Fresh Air Inside
Features - Jun 18, 2025
Best Mobile VPN Apps for Gaming 2025: Complete Guide
Read more
Mobile- Apr 26, 2026
Google Pixel Battery Scandal Illustrates Why Capacity Rules the Smartphone Market
Google Pixel Battery Scandal Illustrates Why Capacity Rules the Smartphone Market
Mobile- Apr 27, 2026
RGB Notification Lights Make a Triumphant Return on Xiaomi's Poco X8 Pro
Xiaomi has delivered a refreshing surprise in the crowded mid-range smartphone market with its latest Poco X8 Pro.
Comments
Sort by Newest | Popular